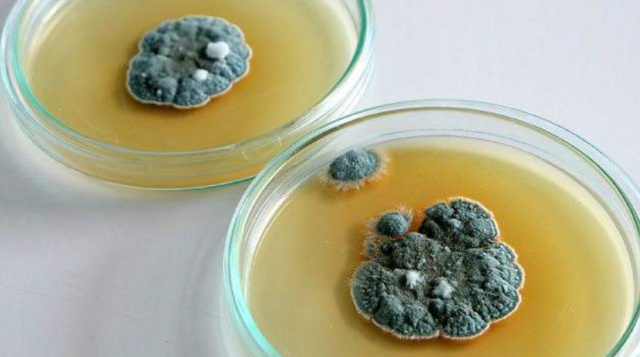
天然"青霉素"被发现了,闲时吃一点,消炎灭菌,预防细胞变化

青霉素的发现

青霉素的发现
图片尺寸1134x471
青霉素的来历p
图片尺寸1080x810
是的,他是青霉素的发现者亚历山大61弗莱明,一次偶然的失误,这位
图片尺寸640x360
弗莱明发现了青霉素
图片尺寸882x490
神奇大发现:弗莱明偶然发现的青霉素,却改变了历史进程
图片尺寸444x304
青霉素的发现ppt
图片尺寸1080x810
青霉素意外的发现
图片尺寸400x300
临床医学 抗菌素合理使用ppt 青霉素的发现者-英国细菌学家弗莱明
图片尺寸1080x810
二战药品青霉素曾卖6000元一克随着中国量产竟变白菜价
图片尺寸1184x664
青霉素的发现与发展
图片尺寸800x450
弗莱明发现青霉素-历史上的9月15日ppt
图片尺寸1080x810
第一种发现并用于疾病治疗的天然抗生素药物是青霉素.
图片尺寸900x661
1青霉素的发现者弗莱明
图片尺寸500x478
天然"青霉素"被发现了,闲时吃一点,消炎灭菌,预防细胞变化
图片尺寸640x357
合格的培养皿 发现青霉素
图片尺寸1080x810
二战药品青霉素曾卖6000元一克随着中国量产竟变白菜价
图片尺寸934x700
青霉素是谁发明的(青霉素的曲折发现历史)-第4张图片-索考网
图片尺寸1176x1020
青霉素发现作用和耐药性
图片尺寸2098x1400
青霉素的发现ppt
图片尺寸813x980
青霉素及头孢ppt
图片尺寸1080x810